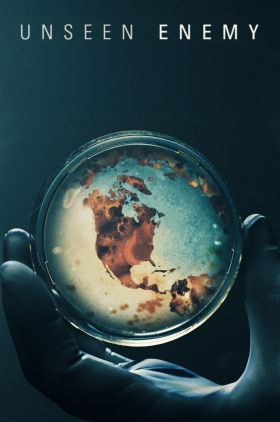
Unseen Enemy

Fahrenheit 9/11 (2004)
دیدگاه «مایکل مور» در رابطه با اتفاقاتی که پس از ماجرای ۱۱ سپـتامبر برای آمریکا افتاد، و اینکه «بوش» چگونه از این حادثه غم انگیز برای به راه انداختن جنگ ناعادلانه در افغانستان و عراق استفاده کرد.
Super Size Me (2004)
مورگان اسپورلوک هنگام بررسی تأثیر صنعت فست فود ، شخصاً پیامدهای رژیم غذایی فقط مک دونالد را به مدت یک ماه بر سلامت خود بررسی می کند.
An Inconvenient Truth (2006)
حقیقت ناراحت کننده نام مستندی که در سال ۲۰۰۶ اکران شد و مربوط به الوده کردن محیط زیست توسط انسان ها میپردازد که چگونه این موجود دو پا خواسته یا ناخواسته خود را در معرض بزرگترین خطرات قرار میدهد بدون اینکه لحظه ای بیندیشد...
Jackass: The Movie (2002)
سری مستندهای جالب و خنده دار ” کله خر ” درمورد یک عده آدم کله خراب است که دور هم جمع شدند و شوخی ها و کار های دیوانه وار انجام میدند...
Sicko (2007)
این فیلم مستندیست که صنعت پرسود و منفعت بهداشت ایالات متحده را به کشورهای دیگر مقایسه می کند...
Jackass Number Two (2006)
جانی ناکسویل و دوستان همیشگی و گروه دیوانه تر از خودش اول در شبکه ی تلویزیونی MTV کارشان را با خل بازی های جنون آمیز شروع کردند. این مستند شامل انجام یک سری کارهای عجیب، خطرناک، مضحک و گاهی تنفربرانگیز و شنیع مقابل دوربین است که ممکن است حتی به مخیله ی آدم های عاقل هم خطور نکند...
The Tinder Swindler (2022)
مردی کلاهبردار که زنان را با استفاده از اپلیکیشن محبوب دوستیابی جذب می کند و آنها را از میلیون ها دلار فریب می دهد...
Exit Through the Gift Shop (2010)
فیلم داستان ارتباط یک مغازهدار عجیب و غریب با یک فیلمساز ناشی را روایت میکند. این مستند داستانی به معرفی "بنکسی" هنرمند مشهور بریتانیایی و هنر خیابانی می پردازد ...
Religulous (2008)
رلیجلس نام مستندی است که در سال 2008 و در سبک طنز (کمدی) به نویسندگی و نقشآفرینی بیل مار ایجاد شد. کارگردانی این اثر را لاری چالز بر عهده داشت. بیل مار با سفر به نقاط مختلفی از جهان، به بررسی محدودهای از دیدگاههایِ متنوعی که دربارهٔ دین در جهان وجود دارد میپردازد...